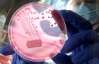
Причинами эпидемии в Германии стали бобы или биогазовые установки

Число умерших в результате инфицирования бактерией E. Coli возросло до 25. Как сообщает France-Presse, в Германии 1 июня и 31 мая скончались две жительницы земли Нижняя Саксония.
Женщины умерли от осложнений, вызванных заражением смертоносной бактерией. Число заболевших превышает 2 тысячи.
Еврокомиссия намерена призвать страны Евросоюза выделить 150 миллионов евро помощи производителям, пострадавшим в результате падения спроса на овощи, вызванного сообщениями о заболевании.
Об этом сообщил комиссар Евросоюза по аграрным вопросам Дациан Чиолос перед проходящим сегодня в Люксембурге чрезвычайным совещанием министров сельского хозяйства стран ЕС, посвященном вспышке кишечного заболевания, вызванного этой бактерией.
Власти Германии, где произошла вспышка болезни, заявили вчера, что источник бактерии пока неизвестен. Ранее в качестве такого источника назывались огурцы, затем - ростки бобовых.

Комментарии
1